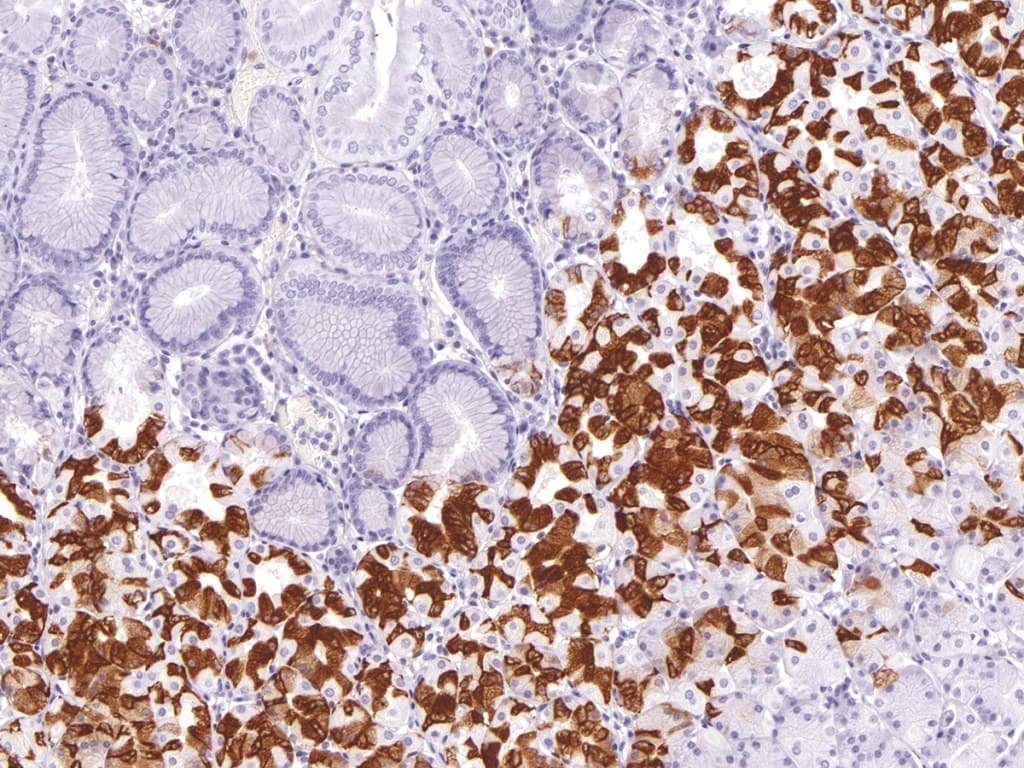

Mucin 6 (MUC6) is a secreted, gel-forming glycoprotein that plays a central role in maintaining the integrity and function of the gastrointestinal (GI) epithelium. Predominantly expressed by mucous neck cells and pyloric glands in the stomach, MUC6 contributes to the formation of a protective mucus barrier that shields epithelial surfaces from gastric acid, digestive enzymes, and microbial colonization. Its heavily O‑glycosylated structure ensures a hydrated gel that lubricates the mucosa and preserves epithelial barrier function.
Biological Significance
MUC6 is essential for normal GI homeostasis. Altered expression has been observed in gastrointestinal neoplasms, including gastric adenocarcinomas and proximal serrated colorectal lesions. In gastric tumors, MUC6 may be reduced, lost, or ectopically expressed depending on the subtype, while in colorectal serrated lesions, MUC6 is typically localized to lower crypts of proximal polyps. These expression patterns provide valuable insights into mucin phenotype classification and tumor differentiation, highlighting MUC6 as a critical biomarker in GI pathology.
Diagnostic Applications
Immunohistochemical detection of MUC6 supports a range of clinical applications:
- Gastric and colorectal neoplasm characterization: Identifies glandular differentiation and defines mucin phenotypes in poorly differentiated adenocarcinomas and serrated lesions.
- Inflammatory bowel disease assessment: Enhances detection of pseudopyloric metaplasia, improving diagnostic accuracy and reproducibility.
- Adjunct to routine histopathology: Differentiates mucinous from non-mucinous tumors and detects aberrant mucin expression across tumor subtypes.
Key Features of Anti-MUC6 CE/IVD Antibodies
Important diagnostic attributes include:
- High specificity for the MUC6 core protein, producing distinct cytoplasmic staining in mucous neck and pyloric gland cells.
- Optimized for reproducible performance on formalin-fixed, paraffin-embedded (FFPE) specimens using standard antigen retrieval protocols.
- Provides diagnostic support for mucin phenotype classification, precancerous lesion identification, and morphological evaluation in both biopsy and resection specimens.